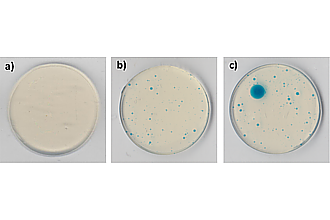
Detailbild zu :  KorroPad

KorroPad
Otto-von-Guericke-Universität Magdeburg
Institut für Werkstoffe, Technologien und Mechanik
Universitätsplatz 2
39106 Magdeburg
Tel.:+49 391 6757071
Gerätebeschreibung
Mit der KorroPad-Prüfung kann die Lochkorrosionsbeständigkeit nichtrostender Stähle auf sehr einfache, schnelle und kostengünstige Weise eingeschätzt werden. Das KorroPad ist damit für Hersteller, Verarbeiter und Anwender nichtrostender Stähle eine interessante Alternative zu zeitintensiven Langzeitprüfungen und komplexen elektrochemischen Untersuchungsmethoden.Das Bild zeigt verschiedene Erscheinungsbilder bei der KorroPad-Prüfung, die unterschiedliche Lochkorrosionsbeständigkeiten anzeigen:
a) stabile Passivschicht b) metastabile Lochkorrosion c) stabile Lochkorrosion
Projekte
Weitere Geräte dieser Struktur
- 3D Laser Scanning Vibrometer
- 3D-Oberflächenmessplatz FORM TALYSURF 120 PC
- 3D-Oberflächenmessplatz MicroCAD
- 6-Komponenten-Messrad
- Biaxialprüfmaschine
- CNC Koordinaten-Messmaschine PMM 866
- CNC-Multisensorkoordinatenmessgerät Video-Check IP 800x400
- CNC-Verzahnungs-Messzentrum EMZ 632
- Computertomographie
- DMG Dreh-Fräszentrum CTX beta 1250 TC
- DMG Mori Bearbeitungszentrum HSC 55 linear
- Elektrodynamischer Shaker (10kN)
- FDM-Drucker Ultimaker 2+
- Formmessgerät TALYROND 250
- Fräs-Lasermaschine DMU 60L Deckel-Maho
- GOM ARAMIS
- GOM Aramis 3D Adjustable 12M
- Hochgeschwindigkeitsfräsmaschine HSM 700 Mikron
- Hochtemperatur -Schutzgasofen LORA
- Impedanzmessrohr
- Induktionstiegelschmelzofen
- Induktionstiegelschmelzofen2
- Kernresonanzspektroskopie AV-300
- Kernresonanzspektroskopie AV-400
- Kernresonanzspektroskopie AV-600
- Koordinaten-Messmaschine TESA MICRO-MS 343
- Laserinterferometersystem ZLM 500
- Makrohärteprüfer
- Messplätze zur Erfassung elektrochemischer Rauschsignale
- Metallographielabor
- Mikro-Computertomograph nanotom S
- Mikrofonarray / akustische Kamera
- Mikrohärteprüfer
- Mini-Testzelle
- Oberflächenmessplatz T1000
- Oberflächenmessplatz T8000
- Planetenkugelmühle PM 100
- Potentiostat
- Pulverdiffraktometer Panalytical X'Pert Pro (Standardmessungen) und Bruker D8 Discover (in situ Messungen, röntgenographische Eigenspannungs- und Texturanalyse, streifender Einfall, Kleinwinkelstreuung)
- Quasistatische Zug- und Druckprüfmaschine
- Raman-Mikroskopie
- Rasterelektronenmikroskop (REM)
- Reflexionsarmer Schallmessraum
- Servohydraulische Prüfmaschine MTS 810 Material Testing System
- Sprühnebelkammer
- Vakuumdifferenzdruck-Gießanlage
- Werkzeugschleifmaschine Walter Helitronic Diamond
- Widerstandstiegelschmelzofen
- elektrochemische Korrosionsmessplätze
